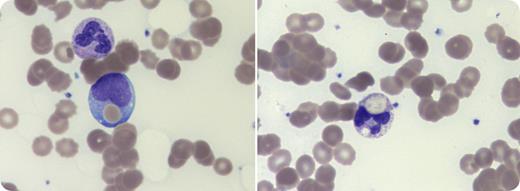
A 27-year-old woman was admitted to the hospital with cough and myalgia. She had no significant past medical history. Blood work showed hemoglobin 97 g/L (reference range, 120-160 g/L), bilirubin 113 µmol/L (reference range, <20 µmol/L), and lactate dehydrogenase 3420 IU/L (reference range, 120-250 IU/L). The patient had acute kidney injury, creatinine (Cr) 368 µmol/L (reference range, 45-90 μmol/L), and estimated glomerular filtration rate (eGFR) 14 mL/min per 1.73 m2 (reference range, >90 mL/min per 1.73 m2). Review of the blood film showed agglutination and erythrophagocytosis (Wright stain, original magnification ×100), suggestive of paroxysmal cold hemoglobinuria. Direct antiglobulin test was positive for C3d, and blood specimens appeared grossly hemolyzed. Nucleic acid amplification on a nasopharyngeal swab was positive for influenza A virus, respiratory syncytial virus, and adenovirus. The patient deteriorated rapidly. Twenty-four hours postadmission, hemoglobin fell to 54 g/L, requiring transfusion, and she developed oliguric renal failure (Cr 607 µmol/L, eGFR 8 mL/min per 1.73 m2), needing urgent hemodialysis. She was commenced on methylprednisolone, followed by oral prednisone with gradual resolution of hemolysis and anemia. Testing confirmed Donath-Landsteiner antibody when her plasma was not grossly hemolytic. Dialysis was ceased and renal function normalized over the ensuing weeks. / Paroxysmal cold hemoglobinuria with renal failure is rare, with only 3 adult cases reported in the literature. This case highlights the acute clinical deterioration that can occur and the blood film features, such as erythrophagocytosis, that may aid diagnosis.

A 27-year-old woman was admitted to the hospital with cough and myalgia. She had no significant past medical history. Blood work showed hemoglobin 97 g/L (reference range, 120-160 g/L), bilirubin 113 µmol/L (reference range, <20 µmol/L), and lactate dehydrogenase 3420 IU/L (reference range, 120-250 IU/L). The patient had acute kidney injury, creatinine (Cr) 368 µmol/L (reference range, 45-90 μmol/L), and estimated glomerular filtration rate (eGFR) 14 mL/min per 1.73 m2 (reference range, >90 mL/min per 1.73 m2). Review of the blood film showed agglutination and erythrophagocytosis (Wright stain, original magnification ×100), suggestive of paroxysmal cold hemoglobinuria. Direct antiglobulin test was positive for C3d, and blood specimens appeared grossly hemolyzed. Nucleic acid amplification on a nasopharyngeal swab was positive for influenza A virus, respiratory syncytial virus, and adenovirus. The patient deteriorated rapidly. Twenty-four hours postadmission, hemoglobin fell to 54 g/L, requiring transfusion, and she developed oliguric renal failure (Cr 607 µmol/L, eGFR 8 mL/min per 1.73 m2), needing urgent hemodialysis. She was commenced on methylprednisolone, followed by oral prednisone with gradual resolution of hemolysis and anemia. Testing confirmed Donath-Landsteiner antibody when her plasma was not grossly hemolytic. Dialysis was ceased and renal function normalized over the ensuing weeks.
Paroxysmal cold hemoglobinuria with renal failure is rare, with only 3 adult cases reported in the literature. This case highlights the acute clinical deterioration that can occur and the blood film features, such as erythrophagocytosis, that may aid diagnosis.
A 27-year-old woman was admitted to the hospital with cough and myalgia. She had no significant past medical history. Blood work showed hemoglobin 97 g/L (reference range, 120-160 g/L), bilirubin 113 µmol/L (reference range, <20 µmol/L), and lactate dehydrogenase 3420 IU/L (reference range, 120-250 IU/L). The patient had acute kidney injury, creatinine (Cr) 368 µmol/L (reference range, 45-90 μmol/L), and estimated glomerular filtration rate (eGFR) 14 mL/min per 1.73 m2 (reference range, >90 mL/min per 1.73 m2). Review of the blood film showed agglutination and erythrophagocytosis (Wright stain, original magnification ×100), suggestive of paroxysmal cold hemoglobinuria. Direct antiglobulin test was positive for C3d, and blood specimens appeared grossly hemolyzed. Nucleic acid amplification on a nasopharyngeal swab was positive for influenza A virus, respiratory syncytial virus, and adenovirus. The patient deteriorated rapidly. Twenty-four hours postadmission, hemoglobin fell to 54 g/L, requiring transfusion, and she developed oliguric renal failure (Cr 607 µmol/L, eGFR 8 mL/min per 1.73 m2), needing urgent hemodialysis. She was commenced on methylprednisolone, followed by oral prednisone with gradual resolution of hemolysis and anemia. Testing confirmed Donath-Landsteiner antibody when her plasma was not grossly hemolytic. Dialysis was ceased and renal function normalized over the ensuing weeks.
Paroxysmal cold hemoglobinuria with renal failure is rare, with only 3 adult cases reported in the literature. This case highlights the acute clinical deterioration that can occur and the blood film features, such as erythrophagocytosis, that may aid diagnosis.
For additional images, visit the ASH Image Bank, a reference and teaching tool that is continually updated with new atlas and case study images. For more information, visit http://imagebank.hematology.org.

This feature is available to Subscribers Only
Sign In or Create an Account Close Modal